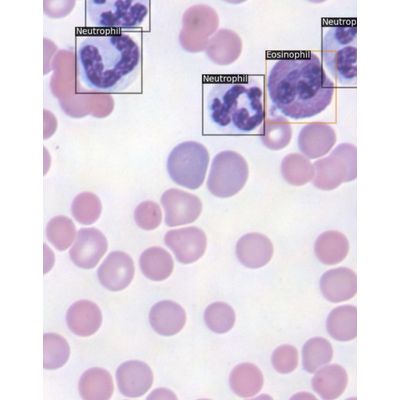

Hematology / General Pathology Service
Moichor automated CBCs harnesses computer vision and AI to achieve results only made possible by high throughput image capture technology. Automating CBCs reduces variability by 10x.
Automated CBC Diagnostics for:
- Avian & Reptile
- Exotic Mammals
- Small Mammals
- Equine
For Avian and reptile patients, Moichor uses its automated imaging and AI algorithm to analyze and provide both cell count and morphology assessment for every sample. These results are verified by our pathology team.
For Mammal patients, Moichor applies a two-pronged approach. First, we run the sample through the gold standard Advia 2120i. Then, it’s run through Moichor’s imaging system and AI algorithm to provide information that can’t be captured by the Advia like complex morphologies and parasites — in essence, a pathologist’s eye analyzes every single slide. Plus, you’ll receive the slide image file for every sample you submit.
Customers can expect a pathology report for each any sample included at no cost.
- Access to patient images
- Comprehensive insights via imaging
- Complementary pathology review
- 3-5x larger sample area
Mammailian CBC W/O Retic: 0.5mL Whole Blood
Mammailian CBC (Retic included): 0.5mL Whole Blood
Blood Lead (all species): 50 μL whole blood
Avian/Exotic CBC: 2 unstained slides, 1/2 filled HCT tube
Small Mammal CBC: 150 μL whole blood
